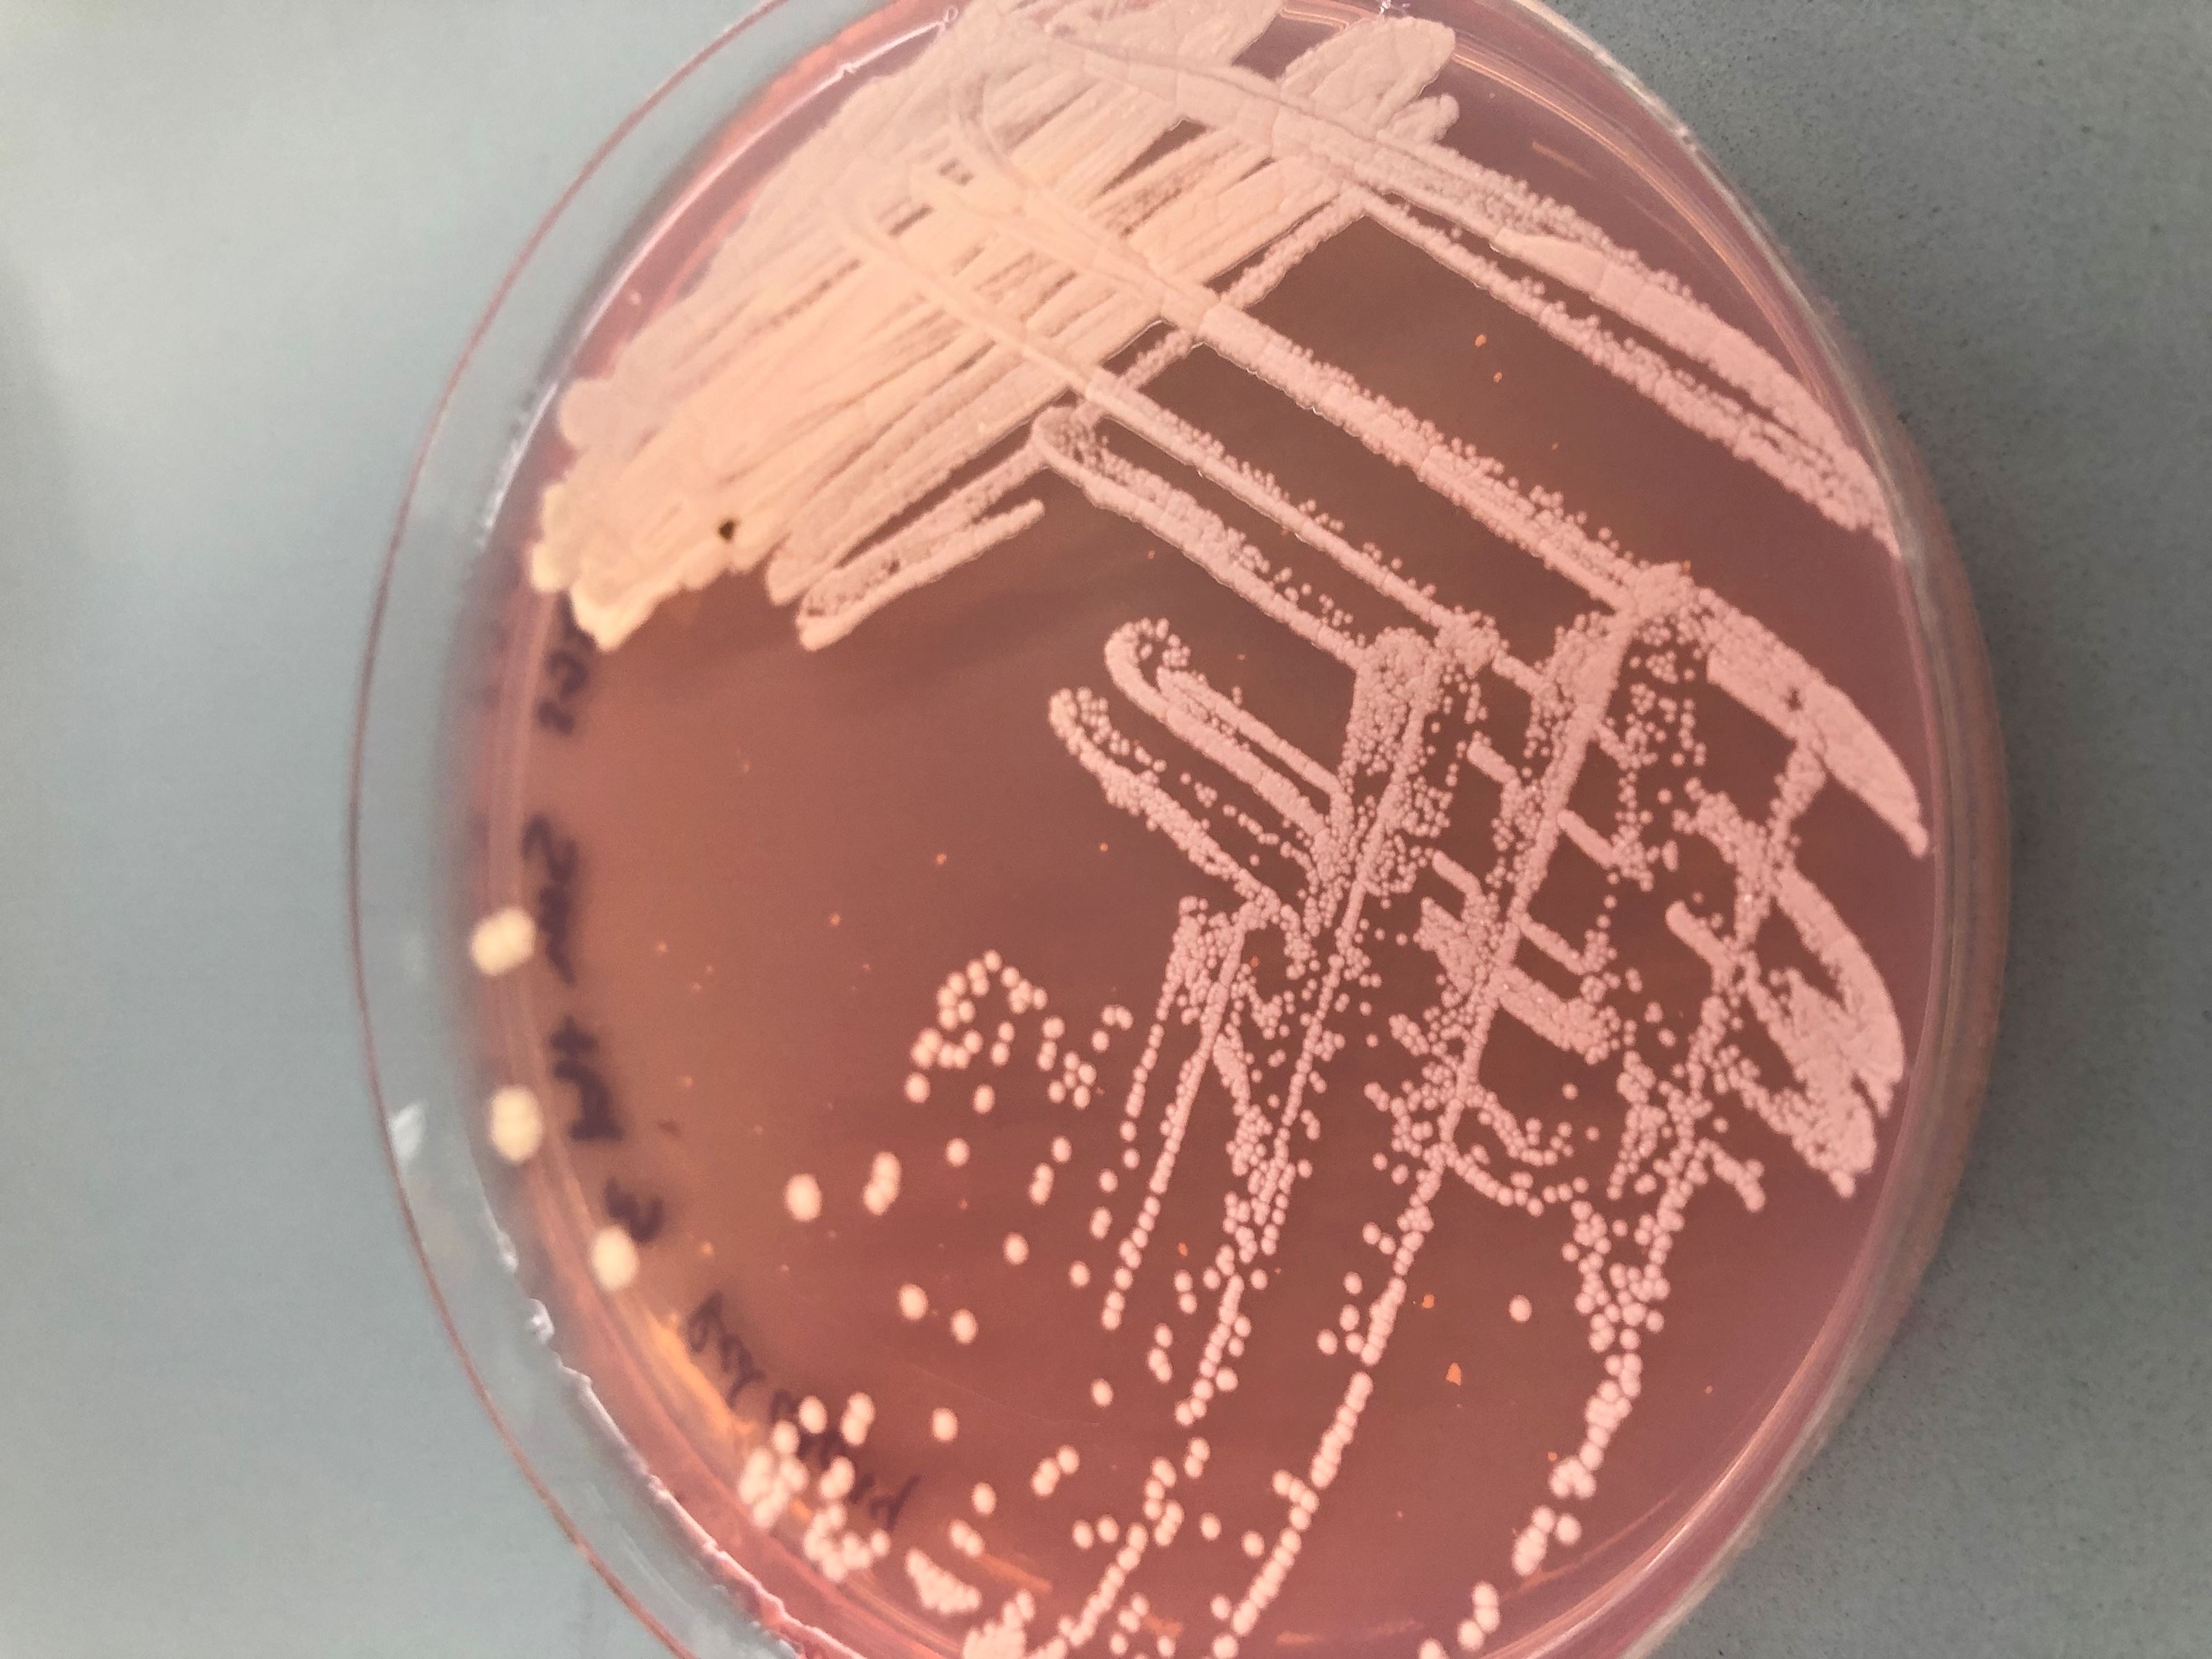

Dr. Michele Culumber

Education
Environmental Biology, Eastern Illinois University, Charleston IL B.S., 1995
Environmental Toxicology, University of Wisconsin – Madison, Ph.D., 2002
Contact Information
Email: mculumber@weber.edu
Phone: 801-626-7795
Office Location:
Tracy Hall Science Center (TY)
Room 450H
Teaching Philosophy & Focus
Microorganisms impact almost every part of our lives and environments. I enjoy sharing the many ways that we interact with microorganisms and hope to capture students' interest and motivate them to become scholars of microbiology. I also hope to encourage students to see how microbiology influences their lives and their careers.
Courses Taught
Search Catalog For Course Details
Research Areas of Interest
I am interested in studying unique microorganisms in unique environments. I've done research on microbes in contaminated groundwater, Hawaiian soils, Peat Bogs, The Great Salt Lake, and Cheddar cheese.
Specific Projects
Recently we identified, and named, a new organism, Lactobacillus wasatchensis, which causes gas development in aging cheese. This appears to be a widespread problem in the cheese industry. We are looking for the source of this organism in the environment and trying to identify its metabolic pathways and mechanisms to inhibit its growth or ability to produce gas. I support the BUILD Dairy program and mentor research students interested in dairy or food science careers. I am also interested in a project that investigates microorganisms fount in the environment such as soil actinomycetes. Recently, I've enjoyed looking for Tardigrades (water bears).
Publications
Culumber, M., McMahon, D.J., Ortakci, F., Montierth, L., Villalba, B., Broadbent, J. and Oberg, C. 2017. Hot topic: Geographical distribution and strain diversity of Lactobacillus wasatchensis isolated from cheese with unwanted gas formation. J. Dairy Sci., 100 (11):8764-8767.
Oberg, C. J., T. S. Oberg, M. C. Culumber, F. Ortakci, J. R. Broadbent and D. J. McMahon. 2016. Lactobacillus wasatchensis sp. nov., a non-starter lactic acid bacteria isolated from aged Cheddar cheese. Int. J. System. Evol. Microbiol. 66:158-164
Referral Websites
BUILD Dairy
American Society for Microbiology
Goats and Soda (NPR blog on Environmental and Global Health)
Science Friday
Advisor & Office Hrs
New Major Advisor
Dr. Matthew Domek
Dr. Michele Culumber
Monday - Friday
8:00 a.m. - 4:30 p.m.
Mailing Address
Weber State University
College of Science
1415 Edvalson St., Dept. 2506
Ogden, UT 84408-2506